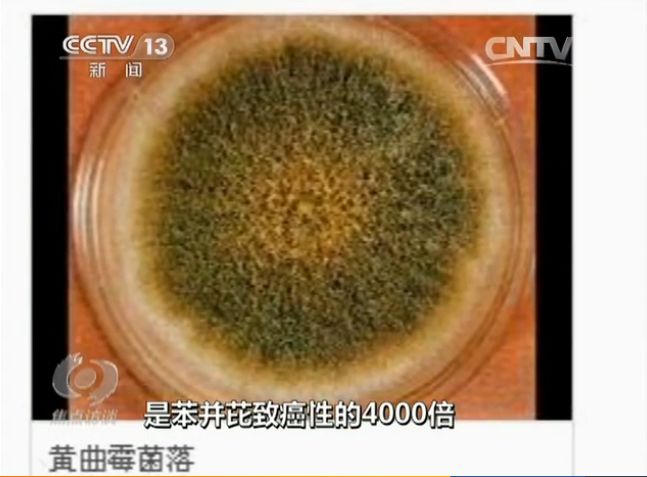
花生油压榨和土榨区别,农村土榨花生油能吃吗

食品安全是现在大家最关心的问题之一,有些消费者甚至觉得只有那些亲眼看到生产过程的食品才是让人放心的食品。现在现场制作、边做边卖的销售模式十分流行,比如榨油的作坊就是典型代表,亲眼看到清澈的油汁流进瓶子好像确实安全可靠,可实际上这样子榨出来的花生油真的靠谱吗?

新闻曾多次曝光在广西梧州、广东肇庆有很多花生油作坊,当着顾客的面现榨现卖,生意很是红火。两斤半花生榨一斤油,两斤半花生至少要12元,而油普遍都10元一斤,价格低廉的秘密就在一个“假”字。这些花生油都有掺棕榈油、大豆油的情况,有的还掺有动物油脂。而这些造假的花生油还有更严重的问题:由于榨油的原料没有好的保存条件容易霉变,生产出来的油储存方式也存在问题,因此一些油里还检测出黄曲霉毒素B1超标。
黄曲霉毒素到底是啥

黄曲霉毒素,是一种很常见的霉菌,广泛存在于土壤当中。黄曲霉本身并没有害,但它的菌丝生长时就会产生毒素,并随着霉菌孢子扩散至空气中传播。黄曲霉最喜欢在潮湿的环境中生长,广西所在的华南地区,出了名的湿热多雨,简直是这种霉菌的天堂。
高温高湿就容易长黄曲霉毒素,一般温度在25℃~35℃,粮食水分偏高的情况下容易长黄曲霉。比如,南方收割玉米的时候,玉米水分高,如果不及时晒干就很容易长黄曲霉毒素B1。黄曲霉毒素B1化学性质相当稳定,很难溶于水,高温高压对其破坏程度也很小,接近300度高温才开始裂解,所以普通的水煮对其基本上没有作用,紫外线对它有一定的破坏力。黄曲霉毒素主要是黄曲霉菌和寄生霉菌产生的次代谢产物,至少有17种,其中黄曲霉毒素B1毒性最大。
黄曲霉毒素B1英文名叫“Aflatoxin B1”,简称“AFB1”。黄曲霉毒素B1的毒性:是氰化钾的10倍、*霜砒**的68倍。黄曲霉毒素B1的致癌力:是标准致癌物二甲基亚硝胺的75倍。1993年,世界卫生组织已将其划定为一类致癌物,这是我们所知的最强的生物致癌剂。黄曲霉毒素伤肝:长期少量的积累会对肝脏造成一定程度的损伤,人类肝癌流行病学数据已经证明,黄曲霉毒素是诱发原发性肝细胞癌的主要因素之一。

了解了上面的性质,
是不是觉得黄曲霉毒素B1是个既恐怖又顽固的东西呢?

所以在生活中我们要尽量少接触黄曲霉污染的东西才是最安全的噢~
黄曲霉毒素有哪些来源?
No.1
花生、玉米

花生和玉米都是容易感染黄曲霉的食物,霉变的花生一定不能吃,如果不小心吃到了一定要用清水漱口,并洗干净双手。更不能直接吃有壳的花生,因为有些霉变的从外面看不出来。选花生时如果发现一包花生里面霉变粒多,建议全部都不要吃了,因为黄曲霉是很难用肉眼看到的,霉变粒会污染周围好的花生粒。建议也少吃存放过久的碎玉米粒,因为玉米破碎后没有种皮保护,更容易滋生黄曲霉毒素。
No.2
五谷杂粮、坚果等

这类食物也容易生长黄曲霉,选择这类食物的时候一定要选择闻起来新鲜、看起来没有明显霉变的,有霉味的也切记不能吃。因为杂粮相对买的人少,所以存放时间会久一点,选购的时候一定要注意闻气味,选择新鲜的杂粮坚果。
No.3
牛奶、食用油等

前几年新闻曾曝光奶粉和食用油的黄曲霉B1超标,大家在选择此类产品时,建议选择正规厂家生产的产品,另外建议不要一直食用同一个品种,经常换种类选择性地吃也不错。
No.4
木质筷子、砧板等

小编曾看过一篇文章,说的是一家几口都得癌症,罪魁祸首就是木质筷子和砧板。原来这一家长期使用竹质筷子、木质砧板,而这些东西又长期清洗不干净,滋生了黄曲霉毒素。建议砧板用完要清洗,有太阳的时候放太阳底下暴晒,平常也需要立起来保证其干燥。
养成好习惯,远离黄曲霉毒素B1
01
勤洗手

除了食物,生活中很多东西都有可能污染有黄曲霉毒素,勤洗手是远离毒素最基本的做法。
02
丢掉霉变的东西

霉变的东西不一定有黄曲霉毒素,但其他很多霉菌都会对身体有害,所以坚决丢掉,不要用水洗掉或者把霉变部分去掉,这是不行的,因为黄曲霉中毒只需要一点点,肉眼看不见的不一定就没有毒素。特别是吃瓜子、花生、坚果等要用手剥,坏的不要吃,尽量减少黄曲霉的污染。
最后,我们来总结一下~


土榨花生油缺少科学的质控和检测流程,所以总体上来说,不如正规生产的花生油安全。
不过,只要你能确保榨油所用的花生足够新鲜没有霉变,并且榨油机也清洗干净,土榨花生油偶尔吃吃也无妨。自己精选的花生土榨出来的花生油相信黄曲霉毒素也是没有的,偶尔吃一点浓香的土榨花生油,感觉也是幸福满满的,但不宜长期食用哦。
当然即使自己土榨的花生油黄曲霉毒素稍微超标了,不多食用也不会立即致癌,量变到质变的过程还是很大的。如果每天吃花生油的话,小编建议还是去大超市买正规出品的花生油,也可以把超市买的花生油和自家土榨的花生油交替着吃。
根据央视《焦点访谈》报道,对于一些不靠谱的土榨花生油,比如上述“在广西梧州、广东肇庆的花生油作坊”榨出的花生油,建议您千万别碰,也不要尝。
供稿:理化检验所
编辑:健康教育与传媒科
(图片来源于网络)